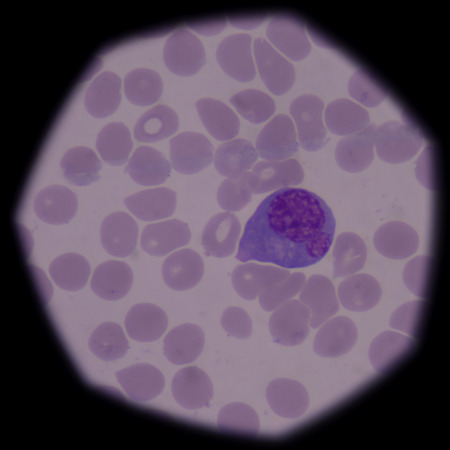
Atypical, or reactive, lymphocytes are lymphocytes that, as a result of antigen stimulation, have become quite large, sometimes more than 30 Âµm in diameter. The cells vary greatly in size and shape.の写真素材

写真素材 - Atypical, or reactive, lymphocytes are lymphocytes that, as a result of antigen stimulation, have become quite large, sometimes more than 30 µm in diameter. The cells vary greatly in size and shape.
作品情報
Atypical, or reactive, lymphocytes are lymphocytes that, as a result of antigen stimulation, have become quite large, sometimes more than 30 µm in diameter. The cells vary greatly in size and shape.
- ID:45491365
- 作品種別:写真
- 作者名:toeytoey
キーワード
- abnormal
- acute
- antigen
- bactericidal
- band
- biology
- blast
- blood
- bone
- cell
- cytoplasm
- decrease
- disease
- eosinophil
- granulation
- health
- hematology
- immune
- infection
- laboratory
- leukemia
- leukocyte
- lobed
- lymphocyte
- marrow
- medical
- medicine
- metamyelocyte
- microbiology
- microcyte
- microscope
- neutrophil
- normal
- nucleus
- organism
- pathology
- platelet
- pmn
- promyelocyte
- red
- segmented
- slide
- smear
- system
- thalassemia
- thalassemias
- white
- atypical lymphocyte
類似作品
White blood cel...
Blood smear of ...
in slide blood ...
White blood cel...
Acute lymphobla...
Mix white blood...
Close up of pur...
A blood smear i...
This image show...
Neutrophil with...
Blurred test tu...
Microscopic Vie...
slide blood sme...
Chromosomes Hum...
eosinophil gran...
Chronic myeloid...
Toxic granulati...
Leukemia cells ...
Blood picture o...
Lymphocyte cell...
Acute promyeloc...
Chronic myeloid...
Neutrophil show...
A blood smear i...
Human blood sme...
Immature and ma...
Blood cancer.bl...
Immature and ma...
Eosinophil
neutrophils. bl...
Leukocyte serie...
Cancer Cell in ...
Immature white...
Human blood sme...
A blood smear i...
Acute promyeloc...
Acute promyeloc...
Chronic myeloid...
Abnormal red bl...
Hodgkins lympho...
Leukemia cells
Chronic myeloid...
Leukemia cells ...
Cancer Cell in ...
White blood cel...
White blood cel...
Blood smear wit...
Inflammation, l...
Acute lymphobla...